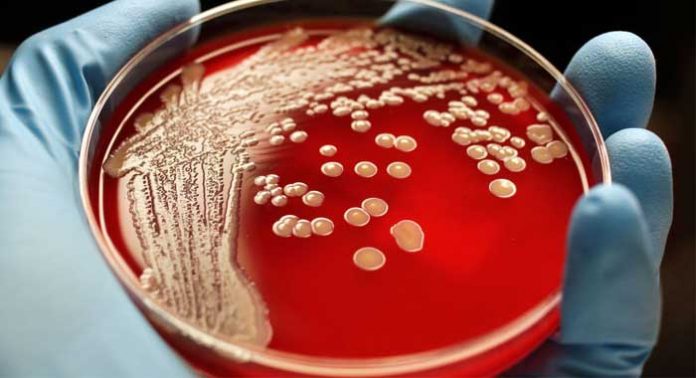

Las infecciones postquirúrgicas son complicaciones graves y potencialmente mortales. Los métodos actuales de lucha contra las infecciones, especialmente frente a los patógenos resistentes a los medicamentos, a menudo se quedan cortos. Nuevas investigaciones, mirando a una estrecha banda de luz ultravioleta podrían ofrecer una solución segura y sencilla.
Una cirugía limpia se refiere a una operación llevada a cabo en un ambiente estéril que no se produce la inflamación, infección o daño tisular inesperado.
Incluso en estas situaciones ideales, se estima que 0,5-10% de los procedimientos resultan en infecciones del sitio quirúrgico (ISQ).
Eso equivale a alrededor de 275.000 pacientes en los Estados Unidos por año. Los individuos con infecciones del sitio quirúrgico tienen una doble tasa de mortalidad respecto a alguien sin una infección.
Un paciente con un ISQ permanece en el hospital, en promedio, 1 semana a más que alguien sin una infección. En total, las ISQ cuestan los EE.UU. hasta U$$ 10 mil millones al año en costes agregados a los pacientes en el hospital.
Se estima que unos 8.200 muertes se atribuyen a las ISQ cada año en los EE.UU.
Los esfuerzos para reducir el número de infecciones han tenido un éxito limitado; con el surgimiento de bacterias resistentes a los fármacos, tales como SARM (Staphylococcus Aureus Resistente a la Meticilina), el problema no muestra signos de desaceleración, y algunos científicos están preocupados de que el problema pueda agravarse.
El Staphylococcus Aureus Resistente a la Meticilina (SARM) – foto de portada -, es una cepa de la bacteria Staphylococcus Aureus que ha adquirido resistencia a varios antibióticos: primero a la penicilina en 1947, y luego a la meticilina. Fue descubierto originalmente en el Reino Unido en 1961 y actualmente está muy propagado. Hoy en día, una nueva cepa ha desarrollado también una resistencia a la vancomicina (SARV), uno de los pocos antibióticos que todavía eran capaces de controlar esta bacteria.
Investigadores de la Universidad de Columbia Medical Center, han dirigido su atención a la luz ultravioleta (UV), como una manera de luchar contra estos invasores quirúrgicos.
Banda específica de luz UV y el SARM
Los científicos han sabido desde hace tiempo que la luz UV tiene la capacidad de matar bacterias, incluso patógenos como el SARM, conocidas como «superbacterias». Sin embargo, las lámparas UV requeridas para este tipo de tratamiento también suponen una amenaza importante para la salud de los pacientes y el personal médico. Pueden causar una serie de problemas de salud, lo más a menudo dañan los ojos y la piel. Por ejemplo, la luz UV se sabe que inducen al cáncer de piel y cataratas.
En los últimos años, los investigadores dirigidos por David J. Brenner, Ph.D., han investigado bandas más estrechas de la luz UV, como una forma de encontrar una alternativa que todavía sea tóxica para los patógenos (citotóxicos), pero segura para la piel y los ojos humanos.
Brenner decidió investigar la «gran luz UVC,» – una banda estrecha de luz ultravioleta con una longitud de onda de alrededor de 200 nanómetros.
Se eligió este rango específico de luz UV, ya que no puede penetrar en la capa muerta de la piel que recubre lo vivo, la piel cada vez mayor, o la capa externa del ojo. Luces de longitudes de onda alrededor de 200 nanómetros son absorbidas con seguridad por las proteínas y otras moléculas en la piel y es incapaz de alcanzar el núcleo de las células.
Sin embargo, las células bacterianas son de entre 10-25 veces más pequeñas que las células humanas y, por lo tanto, todavía susceptibles a los rayos dañinos de la extrema luz UVC.
Banda estrecha de UVC y la seguridad de la piel
En un estudio previo, el equipo encontró que esta gran luz UVC es igual de eficaz en matar el SARM como la luz UV germicida convencional. Los resultados positivos estimularon el equipo en investigar si este rango de longitud de onda podría ser beneficiosa en un entorno clínico.
Aunque Brenner y su equipo habían demostrado previamente que la luz de gran UVC no parece causar daños en un modelo 3-D de la piel humana, querían investigar sus efectos sobre la piel viva. Para ello, se utilizaron ratones sin pelo, cuya piel se sabe que responde de una manera muy similar a los seres humanos».
Los resultados demostraron que la luz de gran UVC no dañan las células sanas de la piel.
«Nuestros resultados ofrecen una posible vía práctica hacia la reducción significativa de las tasas de infección del campo quirúrgico sin riesgo para la salud y la seguridad de los pacientes y el personal médico», explicó el autor principal, David J. Brenner, Ph.D..
Luego, el equipo tiene previsto ampliar esta investigación para entornos quirúrgicos y los animales más grandes, incluyendo los seres humanos. En el futuro, dentro de la misma linea, esperan investigar el uso de gran UVC en la batalla contra los patógenos transportados por el aire, como la tuberculosis y la gripe.
Si los resultados de las próximas fases de las pruebas tienen éxito, podrían anunciar una manera más segura y rentable de gestionar las infecciones y agentes patógenos en una serie de ajustes. Los autores son rápidos para señalar que ahora la luz UVC no eliminará completamente el riesgo de infecciones del sitio quirúrgico, pero recurrir a la esperanza de que van a ahorrar una cantidad significativa de tiempo, dinero y, lo más importante, salvar vidas.
Medical Press ha informado el año pasado sobre un estudio en el que los rayos UV cortan las transmisiones de superbacterias en hospitales:
Rayos UV: corta transmisiones de superbacterias en hospitales






